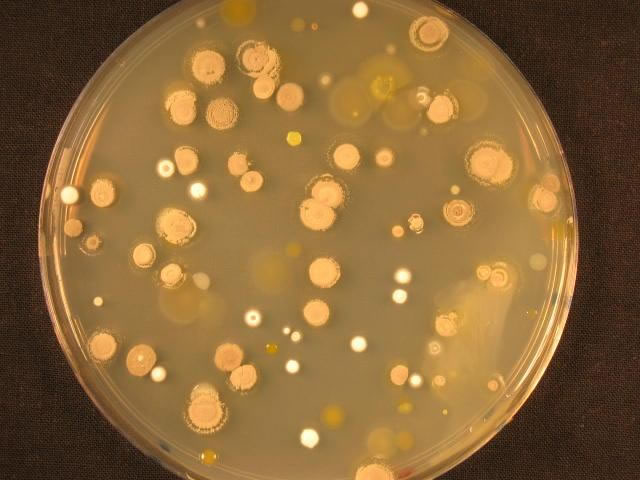

Fitosolum. Biodiversidad y Cambio Global.
Grupo de Investigación constituido por investigadores de cinco departamentos con el objetivo común de analizar las relaciones entre la Biodiversidad y el Cambio Global.

Líneas de Investigación
-
Nuestros objetivos científicos generales están centrados en el estudio de la relaciones entre la diversidad biológica y el medio edáfico y cómo estas relaciones son influidas por el cambio global, cambio climático incluido, y viceversa.
-
Aportamos experiencia en estudios sobre biodiversidad y ecología vegetal y microbiana con especial atención en aquellos aspectos del medio que influyen en su composición y distribución a lo largo de gradientes ambientales en diferentes ecosistemas.
-
En los últimos años hemos incorporado diferentes aspectos relacionados con el cambio global dentro de nuestras líneas de investigación.
Investigadores principales
Miguel Ángel Casermeiro Martínez
José Antonio Molina Abril
_jpg.jpg)
_JPG.jpg)